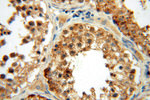
MRPL46 Antibody in Immunohistochemistry (Paraffin) (IHC (P))

Search
Proteintech
MRPL46 Polyclonal Antibody
{{$productOrderCtrl.translations['antibody.pdp.commerceCard.promotion.promotions']}}
{{$productOrderCtrl.translations['antibody.pdp.commerceCard.promotion.viewpromo']}}
{{$productOrderCtrl.translations['antibody.pdp.commerceCard.promotion.promocode']}}: {{promo.promoCode}} {{promo.promoTitle}} {{promo.promoDescription}}. {{$productOrderCtrl.translations['antibody.pdp.commerceCard.promotion.learnmore']}}
产品信息
16611-1-AP
种属反应
宿主/亚型
分类
类型
抗原
偶联物
形式
浓度
规格
纯化类型
保存液
内含物
保存条件
运输条件
产品详细信息
Immunogen sequence: MAAPVRRTL LGVAGGWRRF ERLWAGSLSS RSLALAAAPS SNGSPWRLLG ALCLQRPPVV SKPLTPLQEE MASLLQQIEI ERSLYSDHEL RALDENQRLA KKKADLHDEE DEQDILLAQD LEDMWEQKFL QFKLGARITE ADEKNDRTSL NRKLDRNLVL LVREKFGDQD VWILPQAEWQ PGETLRGTAE RTLATLSENN MEAKFLGNAP CGHYTFKFPQ AMRTESNLGA KVFFFKALLL TGDFSQAGNK GHHVWVTKDE LGDYLKPKYL AQVRRFVSDL (1-279 aa encoded by BC017883)
靶标信息
Mammalian mitochondrial ribosomal proteins are encoded by nuclear genes and help in protein synthesis within the mitochondrion. Mitochondrial ribosomes (mitoribosomes) consist of a small 28S subunit and a large 39S subunit. They have an estimated 75% protein to rRNA composition compared to prokaryotic ribosomes, where this ratio is reversed. Another difference between mammalian mitoribosomes and prokaryotic ribosomes is that the latter contain a 5S rRNA. Among different species, the proteins comprising the mitoribosome differ greatly in sequence, and sometimes in biochemical properties, which prevents easy recognition by sequence homology. This gene encodes a 39S subunit protein.
仅用于科研。不用于诊断过程。未经明确授权不得转售。
生物信息学
蛋白别名: 39S ribosomal protein L46, mitochondrial; L46mt; Large ribosomal subunit protein mL46; mitochondrial large ribosomal subunit protein mL46; MRP-L46; P2ECSL; similar to Arabidopsis decoy protein; unnamed protein product
基因别名: 3110052F15Rik; C15orf4; C80107; LIECG2; mL46; MRPL46; P2ECSL
UniProt ID: (Human) Q9H2W6, (Rat) Q5RK00, (Mouse) Q9EQI8
Entrez Gene ID: (Human) 26589, (Rat) 293054, (Mouse) 67308